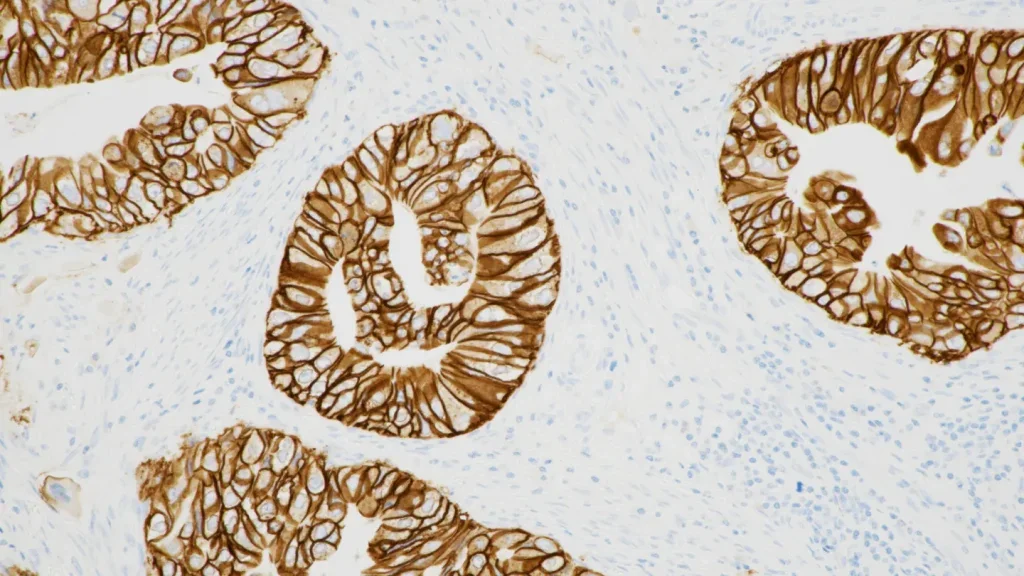

All articles by Manish Kumar
Oxford Nanopore and UK Biobank to launch epigenetic mapping project
The collaboration will map the epigenome of 50,000 participants, providing valuable data to advance disease research and improve patient outcomes
Custom Health and PatchRx partner to build a comprehensive medication intelligence solution
The collaboration merges expertise in medication adherence technologies to create a first-of-its-kind platform designed to improve health outcomes and empower patients
Philips, icometrix partner on AI-driven MRI solution for neurological diagnosis
Both companies will deploy an AI-driven solution for MRI brain scans, enhancing diagnosis and monitoring of neurological conditions like Alzheimer’s and multiple sclerosis
FDA approves Roche’s PATHWAY test as companion diagnostic for BTC
The PATHWAY test is now FDA-approved to identify biliary tract cancer patients eligible for treatment with Jazz Pharmaceuticals’ Ziihera, which secured FDA approval recently
Cortechs.ai partners with Mermaid Beach Radiology to bring precision AI imaging solutions to their MRI and CT services
This partnership introduces precision-driven brain segmentation, volumetric analysis, and longitudinal tracking capabilities to Mermaid Beach Radiology, enabling faster, more accurate insights to enhance patient care
Aulisa Medical launches new monitor camera for enhanced patient care
The monitoring camera enhances patient care with advanced monitoring and improves clinical care, efficiency, and reduces physical check-ins for caregivers
purelyIV launches mobile app for seamless wellness management
The new app allows users to browse services, book IV therapy, manage appointments, purchase packages, and track wellness—all from their mobile device
Bright Light Imaging partners with Alpha Nodus to streamline patient care
The imaging firm has partnered with Alpha Nodus to adopt Gravity Auth and ADS’ MedicsRIS, streamlining workflows, expediting approvals, and improving patient care
Rula Health and Amino Health to expand mental healthcare access in US
Both companies will work together to simplify care access and connect patients with providers who match their preferences and specialise in their conditions
TailorMed secures $40m to expand the largest affordability network into an end-to-end platform, transforming patient access to care nationwide
The funding, led by Windham Capital Partners, will further fuel TailorMed’s mission to eliminate barriers to care for millions of patients